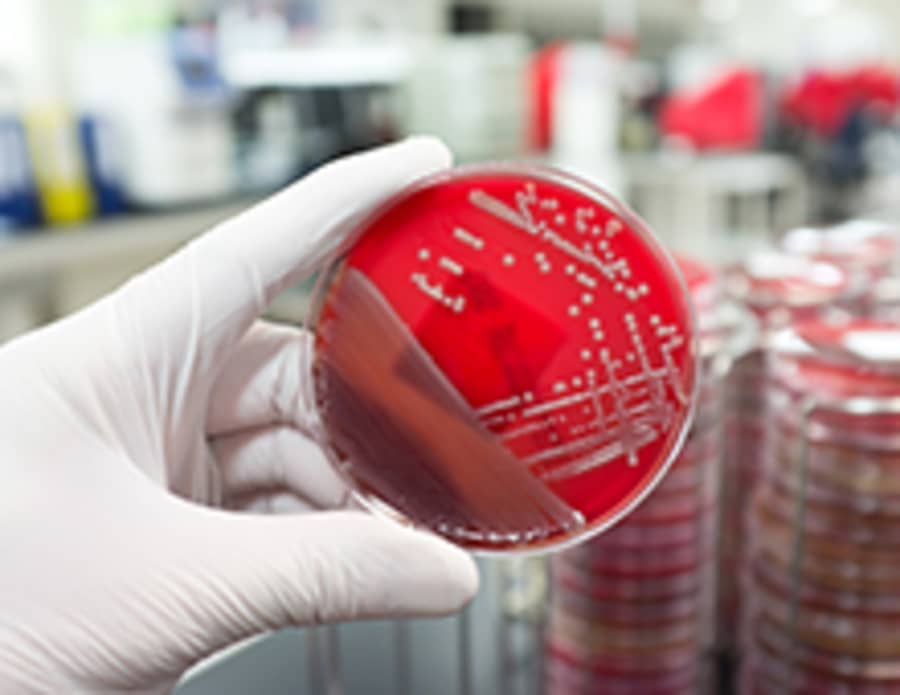
Bacteriegroei in een kweekbakje

Gepubliceerd op:7 juli 2014
Bart Combee, directeur Consumentenbond: 'Met de openbaarmaking van de inspectiegegevens in de horeca gaat een langgekoesterde wens van consumenten in vervulling. Nu weten niet alleen de inspecteurs van de NVWA waar ze met een gerust hart kunnen lunchen, maar kunnen álle consumenten over die informatie beschikken en een afgewogen keuze maken'. De Consumentenbond hoopt dat op korte termijn ook de inspectiegegevens van andere sectoren in de horeca openbaar zullen worden.
De Consumentenbond vindt het een grote stap vooruit dat consumenten de inspectiegegevens via een website en app kunnen raadplegen, maar zal er bij de NVWA op aandringen dat in de toekomst ook op de deur van de horecazaken het oordeel van de NVWA te vinden is. Dit systeem werpt al jaren zijn vruchten af in Denemarken, Groot-Brittannië en New York. Consumenten kunnen zo nog makkelijker ter plekke zien of een horecagelegenheid de hygiëne op orde heeft.
Lees ook:
Openbaarmaking horeca-inspecties goed nieuws voor consumenten
Campagne Kijkje in de keuken